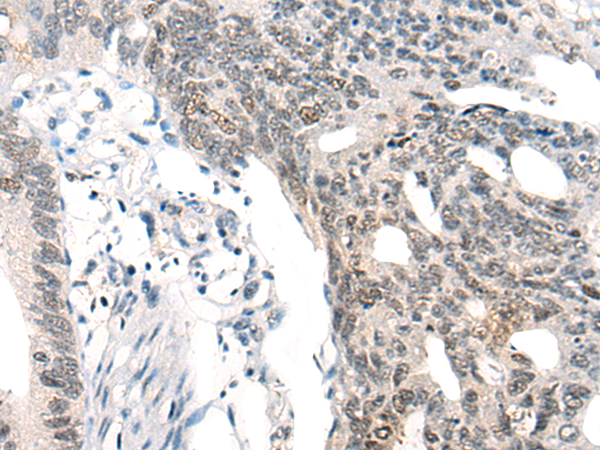

中文名稱: 兔抗MBD2-b多克隆抗體
英文名稱: Anti-MBD2-b rabbit polyclonal antibody
別 名: methyl-CpG binding domain protein 2; DMTase; NY-CO-41
相關(guān)類別: 一抗
儲(chǔ) 存: 冷凍(-20℃)
宿 主: Rabbit
抗 原: MBD2-b
反應(yīng)種屬: Human
標(biāo) 記 物: Unconjugate
克隆類型: rabbit polyclonal
技術(shù)規(guī)格
|
Background: |
DNA methylation is the major modification of eukaryotic genomes and plays an essential role in mammalian development. Human proteins MECP2, MBD1, MBD2, MBD3, and MBD4 comprise a family of nuclear proteins related by the presence in each of a methyl-CpG binding domain (MBD). Each of these proteins, with the exception of MBD3, is capable of binding specifically to methylated DNA. MECP2, MBD1 and MBD2 can also repress transcription from methylated gene promoters. The protein encoded by this gene may function as a mediator of the biological consequences of the methylation signal. It is also reported that the this protein functions as a demethylase to activate transcription, as DNA methylation causes gene silencing. Two transcript variants encoding different isoforms have been found for this gene. |
|
Applications: |
ELISA, IHC |
|
Name of antibody: |
MBD2-b |
|
Immunogen: |
Synthetic peptide of human MBD2-b |
|
Full name: |
methyl-CpG binding domain protein 2 |
|
Synonyms: |
DMTase; NY-CO-41 |
|
SwissProt: |
Q9UBB5 |
|
ELISA Recommended dilution: |
5000-10000 |
|
IHC positive control: |
Human colorectal cancer |
|
IHC Recommend dilution: |
20-100 |
購(gòu)物車
幫助
021-54845833/15800441009
